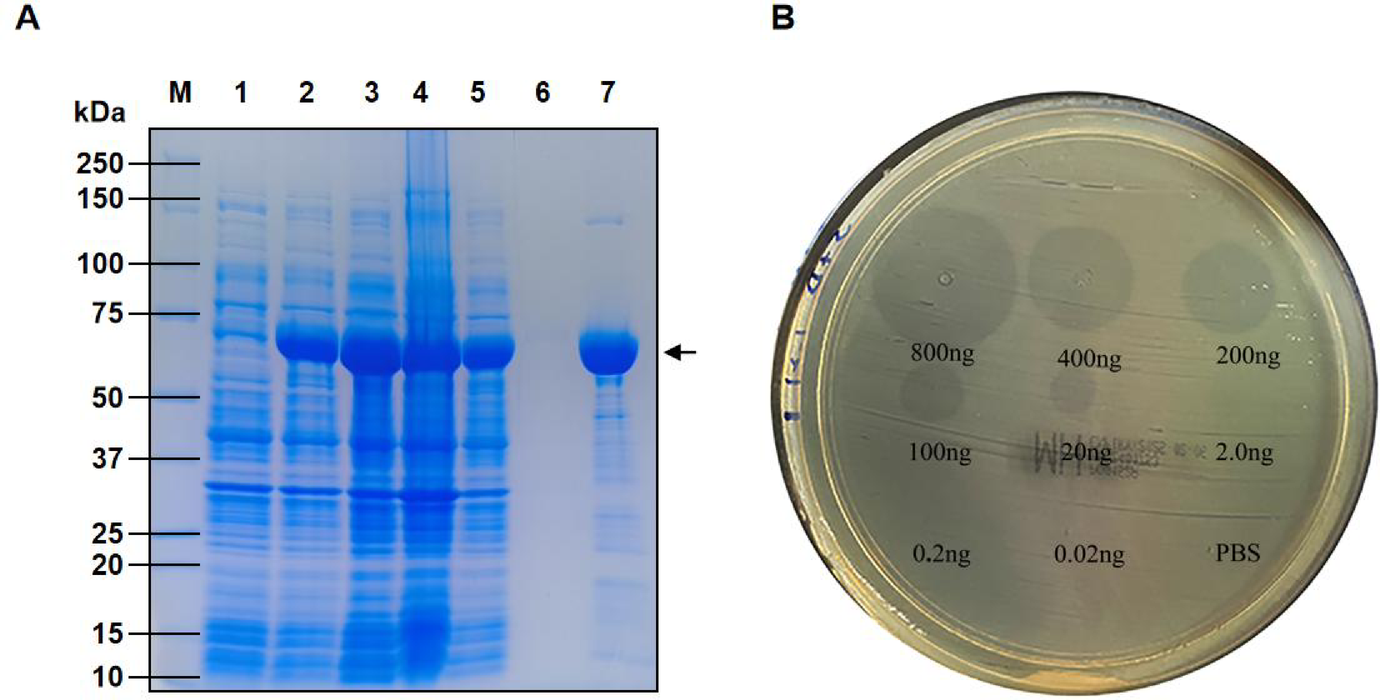
Fig. 4

Fig. 4
From: Identify and characterize a carbapenem-resistant Salmonella enteritidis phage depolymerase Dpo52
Dpo52 overexpression and activity: (A) An SDS-PAGE analysis of purified Dpo52. Lanes: M, 10–250 KDa protein marker; 1: uninduced E. coli BL21 cells; 2: induced E. coli BL21 cells; 3: soluble lysate of the induced E. coli BL21 cells; 4: pellet; 5: flow-through; 6: wash (20 mmol/L imidazole); 7: elute (250 mmol/L imidazole → 72 kDa). (B) Enzyme activity assay of Dpo52. Serial dilutions of Dpo52 (ranging from 0.02 ng to 800 ng) were dropped on lawns of S. enteritidis S3 strain. PBS was used as a control.
